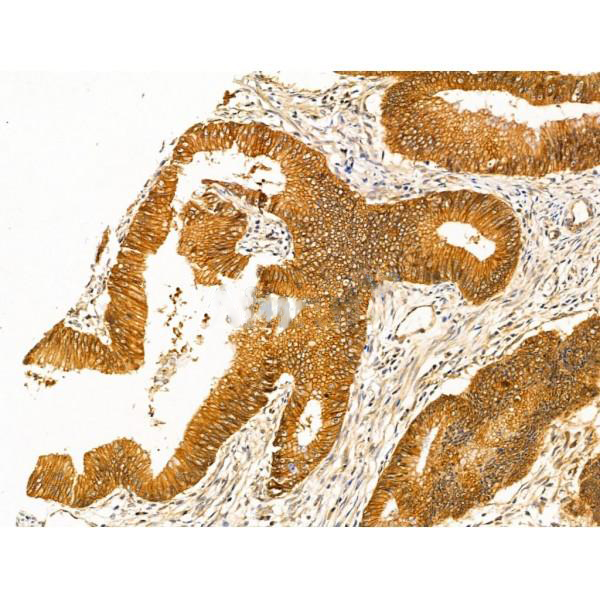

Associates with the cytoplasmic domain of a variety of cadherins. The association of catenins to cadherins produces a complex which is linked to the actin filament network, and which seems to be of primary importance for cadherins cell-adhesion properties. Can associate with both E- and N-cadherins. Originally believed to be a stable component of E-cadherin/catenin adhesion complexes and to mediate the linkage of cadherins to the actin cytoskeleton at adherens junctions. In contrast, cortical actin was found to be much more dynamic than E-cadherin/catenin complexes and CTNNA1 was shown not to bind to F-actin when assembled in the complex suggesting a different linkage between actin and adherens junctions components. The homodimeric form may regulate actin filament assembly and inhibit actin branching by competing with the Arp2/3 complex for binding to actin filaments. May play a crucial role in cell differentiation.
Description
Rabbit polyclonal antibody to alpha 1 Catenin
Applications
WB, IF, ICC, IHC.
Immunogen
alpha 1 Catenin Antibody detects endogenous levels of total alpha 1 Catenin.
Reactivity
Human, Mouse, Rat.
可预测:Pig(100%), Zebrafish(%), Bovine(%), Horse(%), Sheep(%), Rabbit(%), Dog(%), Chicken(%), Xenopus(%)
Molecular weight
100 kDa; 100kD(Calculated).
Host species
Rabbit
Ig class
Immunogen-specific rabbit IgG
Purification
Antigen affinity purification
Full name
alpha 1 Catenin
Synonyms
Alpha E-catenin; Cadherin associated protein 102kDa; Cadherin associated protein; Cadherin-associated protein; CAP 102; CAP102; Catenin (cadherin associated protein) alpha 1 102kDa; Catenin (cadherin associated protein), alpha 1, 102kDa; Catenin alpha 1; Catenin alpha-1; CTNA1_HUMAN; CTNNA 1; Ctnna1; FLJ36832; FLJ52416; MDPT2; NY REN 13 antigen; OTTHUMP00000224141; OTTHUMP00000224147; Renal carcinoma antigen NY REN 13; Renal carcinoma antigen NY-REN-13;
Storage
Rabbit IgG in phosphate buffered saline , pH 7.4, 150mM NaCl, 0.02% sodium azide and 50% glycerol. Store at -20 °C. Stable for 12 months from date of receipt.
Swissprot
P35221




 产品订购:
产品订购:
 渠道电话:
渠道电话: